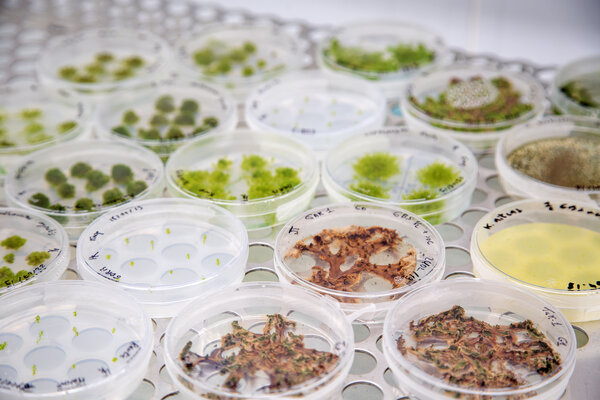
Inauguration de Recherche Data Gouv

Open Access Month 2023: Save the date
Le mois sur l'Open access et la science ouverte aura lieu à l'Université de Strasbourg du 3 au 31 octobre 2023
Vous êtes ici :

Le mois sur l'Open access et la science ouverte aura lieu à l'Université de Strasbourg du 3 au 31 octobre 2023

On May 23, the Council of EU has adopted conclusions on the ‘high quality, transparent, open, trustworthy and equitable scholarly publishing’, in which it calls for immediate and unrestricted open access in publishing research involving public funds.

L'Université de Strasbourg vous propose des rencontres, webinaires et formations sur les données de recherche du 12 au 30 juin 2023.

Vous vous apprêtez à publier un article dans une revue Wiley ou Hindawi ?

Participez au programme de travail HORIZON-INFRA-EOSC 2023/2024

Le chargé de mission Services et infrastructures pour les données de recherche de l'Université vous explique l'engagement de l'Unistra au sein de l'association EOSC

À l'occasion de la semaine internationale Love Data Week 2023, venez échanger sur l'ouverture des données de recherche, codes source et logiciels de recherche dans des rendez-vous variés

L’appel à projets du Fond national pour la science ouverte (FNSO) est ouvert jusqu’au 22 février 2023. Il bénéficie d’un co-financement de l’Agence nationale de la recherche (ANR) en soutien aux projets qui relèvent du modèle diamant.

![[Translate to English:] Répertoire de serveurs de preprints [Translate to English:] Répertoire de serveurs de preprints](/websites/_processed_/3/7/csm_equipe03_0cbecabf64.jpg)
Consult the directory of preprint servers maintained by the Center for Direct Scientific Communication(CCSD) and the Confederation of Open Access Repositories (COAR)
![[Translate to English:] European University Association Open Science Agenda 2025 [Translate to English:] European University Association Open Science Agenda 2025](/websites/_processed_/1/6/csm_RS62432_Inauguration_fresque_Journee_Europe_8195_ea1ee5019e.jpg)
Discover the 2025 agenda of open science actions to be led by the European University Association (EUA)

Les webinaires sont disponibles sur la plate-forme vidéos de l'Université POD

cOAlition S is monitoring developments in the Open Science landscape and is seeking feedback from the research community about their experiences when publishing
Découvrez la plateforme nationale fédérée des données de recherche "Recherche Data Gouv"

OpenAIRE has prepared three guides aimed at researchers who wish to take part in funding calls.

Le Ministère de l'Enseignement Supérieur et de la Recherche (MESR) a annoncé un soutien fort pour le projet de l'Atelier de la donnée Alsace

The Sponsoring Consortium for Open Access Publishing in Particle Physics (SCOAP3)—the world’s largest disciplinary open access initiative—has reached the milestone of over 50’000 research articles published

Participez aux ateliers de la semaine numérique des URFIST du 13 au 16 juin 2022

Consultez les webinars sur le site de pod.unistra.fr

L'Université de Strasbourg et l'Université de Haute-Alsace travaillent de concert pour vous proposer 4 webinars sur les données de recherche tout ce mois-ci. Rejoignez-nous en direct pour interagir avec les intervenants les 6, 13, 17 et 20 mai